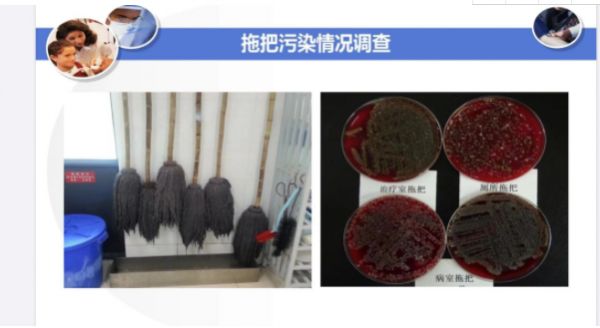

预防新型冠状病毒肺炎,务必做好家里的有效除菌
临近春节,除了返乡与春运等春节关键词,近两天由武汉爆发的新型冠状病毒肺炎疫情也引发持续关注,截止1月20日 18时,我国境内累计报告发现新型冠状病毒感染的肺炎病例224例。
截止目前各方专家仍对疫情透露出积极信号, 1月20日晚,国家卫健委高级别专家组组长钟南山在连线中表示,此次的新型冠状病毒与此前肆虐的SARS是完全不同的两种病毒,传染性没那么强,目前是防控的关键时期。采取必要的预防措施,可有效控制病毒扩散,减少感染可能性。
面对疫情,鲨客提醒大家不必恐慌。重点是做好自身和家人的预防。除了注意个人卫生如勤洗手、出门佩戴合适的医用口罩外,春节期间走亲访友增多,家里的卫生也需高度重视,外出携带回来的细菌、开窗通风时带入的粉尘很容易聚集在家里的地面上,如果不进行及时有效的清洁,会威胁健康。

如何才能有效去除地面细菌又不危害家人健康呢?一般大家会想到两种方式,即传统的拖把拖地或者使用化学制剂喷洒在地面上。但殊不知,使用化学制剂有可能产生二次危害,不利于家里的老人小孩以及免疫力低的家人的呼吸道健康。
对于中国家庭来说,传统拖把仍然司空见惯。然而,传统拖把清洁不彻底反而容易滋生细菌,越拖越脏。鲨客致力于改变这一难题,发明了全新的“拖把新物种”——鲨客蒸汽除菌拖把,通过高温蒸汽除菌,产生120度高温蒸汽,可达到99.99%的除菌率及100%的除螨率;同时还能利用大蒸汽定点喷射技术与强效抓污技术,对地板上的顽固污渍进行快速溶解与抓取吸附,即拖即干,丝毫不留水渍污渍,杜绝二次污染。帮助你从此彻底清除家里的细菌烦恼。
据悉,鲨客蒸汽拖把还有多种功能,既是除菌拖把,还可以搭配不同配件充当除螨仪、厨房油污清洁机、挂烫机。一机多用,堪称居家多功能清洁机,实现全屋清洁。在疫情扩散时期对于家庭除菌来说更是一个最好的选择,帮助守护室内健康免于细菌滋扰,更好的预防新型冠状病毒。
这款产品上市一年多来备受好评,尤其深受母婴家庭的喜爱。截至目前鲨客蒸汽除菌拖把更是连续10个月位居天猫行业TOP1位置。鲨客负责人表示:“我们在反复的用户调研中发现,使用蒸汽拖把是健康可行且有效清除细菌的方式,我们希望能帮助更多的消费者做好日常除菌,在特殊时期也无需恐慌。“
网址:预防新型冠状病毒肺炎,务必做好家里的有效除菌 https://www.jiaju82.com/news-view-id-687095.html

